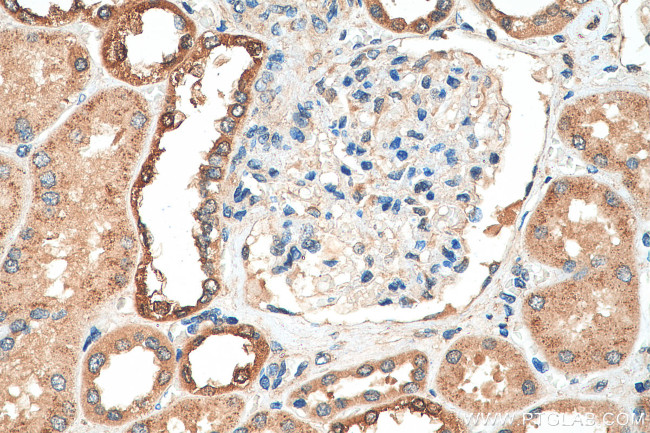
PADI2 Antibody in Immunohistochemistry (Paraffin) (IHC (P))
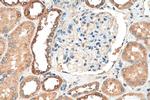
PADI2 Antibody in Immunohistochemistry (Paraffin) (IHC (P))

Search
Proteintech
PADI2 Polyclonal Antibody
{{$productOrderCtrl.translations['antibody.pdp.commerceCard.promotion.promotions']}}
{{$productOrderCtrl.translations['antibody.pdp.commerceCard.promotion.viewpromo']}}
{{$productOrderCtrl.translations['antibody.pdp.commerceCard.promotion.promocode']}}: {{promo.promoCode}} {{promo.promoTitle}} {{promo.promoDescription}}. {{$productOrderCtrl.translations['antibody.pdp.commerceCard.promotion.learnmore']}}
产品信息
29169-1-AP
种属反应
宿主/亚型
分类
类型
抗原
偶联物
形式
浓度
规格
纯化类型
保存液
内含物
保存条件
运输条件
产品详细信息
Aliquoting is unnecessary for -20°C storage.
靶标信息
This gene encodes a member of the peptidyl arginine deiminase family of enzymes, which catalyze the post-translational deimination of proteins by converting arginine residues into citrullines in the presence of calcium ions. The family members have distinct substrate specificities and tissue-specific expression patterns. The type II enzyme is the most widely expressed family member. Known substrates for this enzyme include myelin basic protein in the central nervous system and vimentin in skeletal muscle and macrophages. This enzyme is thought to play a role in the onset and progression of neurodegenerative human disorders, including Alzheimer disease and multiple sclerosis, and it has also been implicated in glaucoma pathogenesis. This gene exists in a cluster with four other paralogous genes.
仅用于科研。不用于诊断过程。未经明确授权不得转售。
篇参考文献 (0)
生物信息学
蛋白别名: PAD type II; PAD-H19; peptidyl arginine deiminase, type 2; peptidyl arginine deiminase, type II; peptidyl arginine deiminase, type II; PAD type II; Peptidylarginine deiminase II; Protein-arginine deiminase type II; Protein-arginine deiminase type-2; RP1-37C10.6; unnamed protein product
基因别名: KIAA0994; mKIAA0994; PAD-H19; PAD2; PADI2; Pdi; PDI2
UniProt ID: (Human) Q9Y2J8, (Rat) P20717, (Mouse) Q08642
Entrez Gene ID: (Human) 11240, (Rat) 29511, (Mouse) 18600